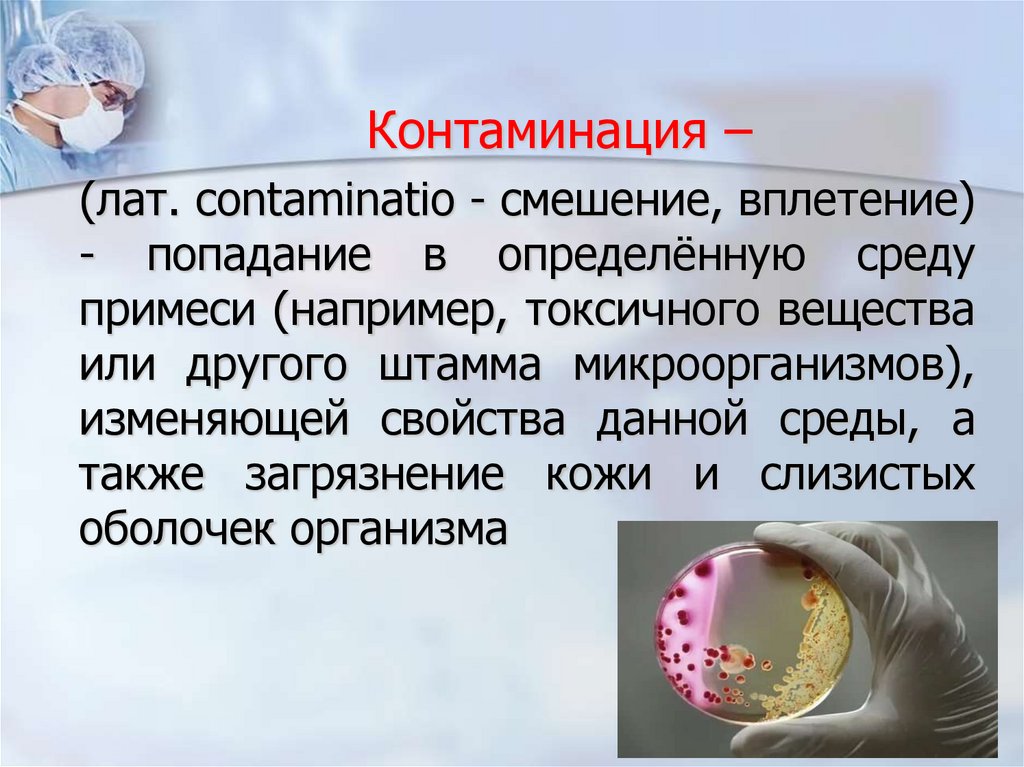
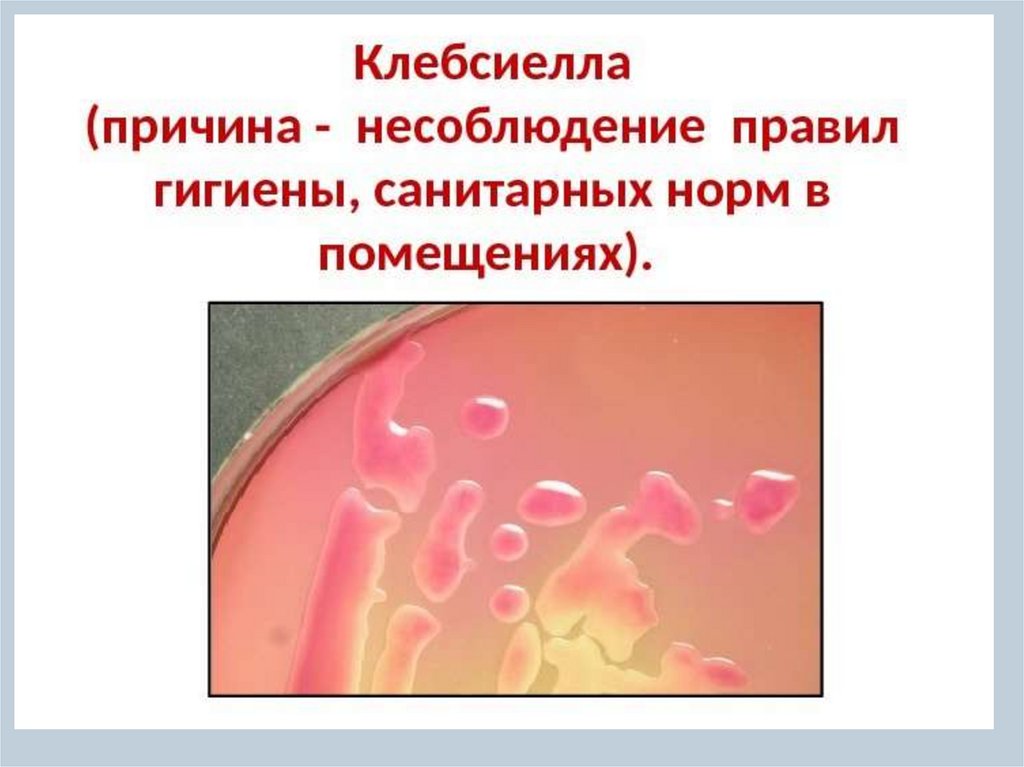

Similar presentations:
Инфекционная безопасность в медицинских организациях
1. ИНФЕКЦИОННАЯ БЕЗОПАСНОСТЬ В МЕДИЦИНСКИХ ОРГАНИЗАЦИЯХ
Ассистент кафедры Сестринского дела с курсом социальных дисциплинВолочаева Марина Владимировна
2.
«Стратегической задачейздравоохранения является
обеспечение качества медицинской
помощи и создание безопасной
среды пребывания для пациентов и
персонала в организациях,
осуществляющих медицинскую
деятельность» (Национальная
концепция профилактики инфекций,
связанных с оказанием медицинской
помощи, 2011 г. )
3.
Регламентирующие нормативные документыФедеральный закон РФ от 21.11.2011 N 323-ФЗ
«Об основах охраны здоровья граждан в Российской
Федерации»
Федеральный закон РФ от 30.03.1999 г. N 52-ФЗ
«О санитарно-эпидемиологическом благополучии
населения» (с изменениями от 9 мая 2005 г.)
Концепция профилактики инфекций,
связанных с оказанием медицинской
помощи от 06.11.2011
4.
Регламентирующие нормативные документыСП 2.1.3678-20
«Санитарно-эпидемиологические
требования
к
эксплуатации
помещений,
зданий,
сооружений,
оборудования и транспорта, а также условиям
деятельности
хозяйствующих
субъектов,
осуществляющих продажу товаров, выполнение работ
или оказание услуг»
с 01.01.2021 до 01.01.2027
СанПиН 3.3686-21
«Санитарно-эпидемиологические
требования
профилактике инфекционных болезней»
с 01.09.2021 до 01.09.2027
по
5.
Регламентирующие нормативные документыСанПиН 2.1.3684-21
"Санитарно-эпидемиологические
требования
к
содержанию
территорий
городских
и
сельских
поселений, к водным объектам, питьевой воде и
питьевому водоснабжению, атмосферному воздуху,
почвам,
жилым
помещениям,
эксплуатации
производственных,
общественных
помещений,
организации
и
проведению
санитарнопротивоэпидемических
(профилактических)
мероприятий"
с 01 марта 2021 до 01 марта 2027
6.
Регламентирующие нормативные документыПриказ Министерства здравоохранения Российской
Федерации от 28.01.2021г. №29н
«Об утверждении Порядка проведения обязательных
предварительных и периодических
медицинских осмотров
работников, предусмотренных частью четвертой статьи 213
Трудового кодекса Российской Федерации, перечня
медицинских противопоказаний к осуществлению работ с
вредными и (или) опасными производственными
факторами, а так же работам, при выполнении которых
проводятся обязательные предварительные и
периодические медицинские осмотры»
с 1 апреля 2021 г. и действует до 1 апреля 2027 г.
7. Приказ Министерства здравоохранения РФ от 28.01.2021г. №29н
Приказ Министерства здравоохранения РФот 28.01.2021г. №29н
Обязательные предварительные медицинские осмотры
(обследования) при поступлении на работу проводятся с целью
определения соответствия состояния здоровья лица, поступающего
на работу, поручаемой ему работе
Обязательные периодические медицинские осмотры (обследования)
проводятся в целях динамического наблюдения за состоянием
здоровья работников, своевременного выявления начальных форм
профессиональных заболеваний, ранних признаков воздействия
вредных и (или) опасных производственных факторов рабочей
среды, трудового процесса на состояние здоровья работников в
целях формирования групп риска развития профессиональных
заболеваний, выявления медицинских противопоказаний к
осуществлению отдельных видов работ
п. 27 Работы в медицинских организациях - 1 раз в год
8.
9.
Виды и формы дезинфекции• Профилактическая
- плановая
- внеплановая
- по эпидемиологическим показаниям
- по санитарно-гигиеническим показаниям
• Очаговая
- текущая
- заключительная
Режим дезинфекции — определенный концентрации
дезинфекционного раствора, температуры
насыщенного пара или воздуха, экспозиции,
способствующих уничтожению возбудителей
10.
11.
Плановая профилактическаядезинфекция
- проводится систематически в МО при отсутствии в них ВБИ, когда
источник возбудителя не выявлен и возбудитель не выделен, с целью:
- уменьшения микробной обсемененности объектов
внутрибольничной среды и предупреждения
возможности размножения микроорганизмов
- предупреждения распространения
микроорганизмов через изделия медицинского
назначения, руки и кожные покровы медицинского
персонала и больных
- освобождения помещений МО и окружающей
территории от членистоногих и грызунов
12.
При плановой профилактической дезинфекциив МО проводится:
- обеззараживание всех видов поверхностей
внутрибольничной среды, обеспечивающее гибель
санитарно-показательных бактерий и уменьшение
контаминации микроорганизмами различных объектов, в
том числе воздуха, предметов ухода за больными,
посуды и других;
- обеззараживание изделий медицинского назначения
(поверхностей, каналов и полостей) с целью
умерщвления бактерий и вирусов (в том числе
возбудителей парентеральных вирусных гепатитов, ВИЧинфекции); обеззараживанию подлежат все изделия
медицинского назначения, включая эндоскопы и
инструменты к ним, после их использования у пациента;
13.
При плановой профилактической дезинфекциив МО проводится:
- дезинфекция высокого уровня эндоскопов (ДВУ),
используемых в диагностических целях (без
нарушения целости тканей, то есть при
"нестерильных" эндоскопических манипуляциях),
обеспечивающая гибель всех вирусов, грибов рода
Кандида, вегетативных форм бактерий и большинства
споровых форм микроорганизмов;
- гигиеническая обработка рук медицинского персонала;
- обработка рук хирургов и других лиц, участвующих в
проведении оперативных вмешательств и приеме
родов;
14.
При плановой профилактической дезинфекциив МО проводится:
- обработка операционного и инъекционного полей;
- полная или частичная санитарная обработка кожных
покровов;
- обеззараживание медицинских отходов классов;
- дезинсекция, обеспечивающая освобождение или
снижение численности членистоногих в помещении и
на окружающей территории;
- дератизация, обеспечивающая освобождение
помещений от грызунов и снижение их численности
на окружающей территории
15.
Текущая уборка в помещениях проводят по режимам,обеспечивающим гибель бактериальной микрофлоры.
При появлении в стационаре ВБИ — по режиму, эффективному в
отношении возбудителя соответствующей инфекции.
При дезинфекции объектов, загрязненных кровью и другими
биологическими субстратами, представляющими опасность в
распространении парентеральных вирусных гепатитов и ВИЧинфекции, следует применять дезинфицирующие средства по
противовирусному режиму.
Целесообразно использовать дезинфицирующие средства с моющими
свойствами, что позволяет объединить обеззараживание объекта
с его мойкой.
При проведении текущих уборок поверхности в помещениях,
приборов, оборудования и другого дезинфицируют способом
протирания
16.
17.
18.
Профилактическая дезинфекция поэпидемиологическим показаниям
- проводится с целью не допустить распространения
возбудителей ВБИ и их переносчиков в отделениях
(палатах) из соседних отделений (палат)
Проводится с учетом эпидемиологических
особенностей конкретной внутрибольничной
инфекции (инкубационный период, устойчивость и
длительность выживания возбудителя на объектах,
имеющих наибольшее эпидемиологическое
значение) и режимов применения средств
обеззараживания (дезинфекции, дезинсекции,
дератизации).
19.
Профилактическая дезинфекцияпо санитарно-гигиеническим показаниям
-проводится как разовое мероприятие в помещениях организаций,
находящихся в неудовлетворительном санитарном состоянии, по
методике проведения генеральных уборок
Генеральная уборка - осуществляется с целью
удаления загрязнений и снижения микробной
обсемененности в помещениях организаций
Проводится мытье, очистка и обеззараживание
поверхностей помещений (в том числе труднодоступных),
дверей, мебели, оборудования (осветительных
приборов), аппаратуры с использованием моющих и
дезинфицирующих средств и последующим
обеззараживанием воздуха (бактерицидные облучатели)
20.
Генеральная уборкаГенеральная уборка функциональных помещений, палат
и кабинетов проводится по графику не реже одного раза
в месяц;
операционных блоков, перевязочных, родильных залов,
процедурных, манипуляционных, стерилизационных один раз в неделю
При генеральной уборке режимы применения
дезинфицирующих средств определяются с учетом
профиля стационара и микробной контаминации
объектов
Проведение генеральных уборок фиксируют в журналах
21. Генеральная уборка
Генеральные уборки в палатных отделениях (кроме инфекционных),врачебных кабинетах, административно-хозяйственных помещениях,
отделениях и кабинетах физиотерапии и функциональной
диагностики и других проводят не реже одного раза в 30
календарных дней дезинфицирующими средствами по режимам,
предусмотренным для профилактики и борьбы с бактериальными
инфекциями, а в инфекционных отделениях - по режимам,
рекомендованным для конкретных возбудителей.
При генеральной уборке проводят мытье, очистку и обеззараживание
поверхностей помещений (в том числе труднодоступных), дверей (в
том числе наличников), окон (с внутренней стороны), плинтусов,
мебели, оборудования (в том числе осветительных приборов),
аппаратуры с использованием моющих и дезинфицирующих средств
(или дезинфицирующих средств с моющими свойствами) с
последующим обеззараживанием воздуха
22.
23.
Очаговая дезинфекция- проводится при выявлении источника инфекции (больные, носители)
в стационарах (отделениях), амбулаторно-поликлинических
организациях любого профиля с учетом эпидемиологических
особенностей инфекции и механизма передачи ее возбудителя
Целью очаговой дезинфекции является предупреждение
распространения возбудителей инфекций от больных
(носителей) с их выделениями и через объекты, имевшие контакт
с больными в стационаре (отделении) и за его пределами
При очаговой дезинфекции обеззараживаются различные
объекты, имеющие эпидемиологическое значение в передаче
возбудителя; проводится гигиеническая обработка рук
медицинского персонала, полная или частичная обработка
кожных покровов больных и персонала; дезинсекция и
дератизация
Очаговая дезинфекция осуществляется в формах текущей и
заключительной очаговой дезинфекции
24.
25.
Текущая очаговая дезинфекцияобъектов внутрибольничной среды в окружении больного проводится
с момента выявления у больного внутрибольничной инфекции и до
выписки (или перевода в другое отделение/стационар)
В ходе текущей очаговой дезинфекции проводится
систематическое обеззараживание потенциально
контаминированных выделений больного и всех
объектов внутрибольничной среды, с которыми больной
имел контакт: изделий медицинского назначения,
предметов ухода, посуды, белья, поверхностей в
помещениях, в том числе мебели и оборудования,
обеззараживание медицинских отходов класса Б и В,
дезинсекция и дератизация. При текущей дезинфекции
проводится гигиеническая обработка рук медицинского
персонала, полная или частичная обработка кожных
покровов больных и персонала, инъекционного поля
26.
Заключительная очаговая дезинфекция - проводитсяпосле выписки, смерти или перевода больного в другое отделение
или стационар с целью обеззараживания объектов
внутрибольничной среды, с которыми он контактировал в процессе
пребывания в стационаре
- обеззараживаются поверхности помещений, в которых
находился больной, и места общего пользования; поверхности
оборудования и приборов; изделия медицинского назначения;
предметы ухода за больным, медицинские отходы
- обеззараживаются в дезинфекционных камерах постельные
принадлежности, нательное белье и вещи больного,
выдаваемые ему перед выпиской
- обеззараживается санитарный транспорт, перевозивший
больного
- проводится полная или частичная санитарная обработка
кожных покровов больных перед выпиской
- проводится дезинсекция и дератизация
27.
Дезинфекционная деятельностьпредусматривает организацию и осуществление работ и
услуг, включающих борьбу с патогенными
микроорганизмами, возбудителями инвазионных
болезней, грызунами и их эктопаразитами,
кровососущими членистоногими и другими насекомыми,
имеющими медицинское значение, разработку,
испытание, производство, хранение, транспортирование,
реализацию, применение, уничтожение и утилизацию
средств, оборудования, материалов для дезинфекции,
предстерилизационной очистки, стерилизации,
дезинсекции, дезинвазии, дератизации, отпугивания, а
также контроль за этими работами и услугами
28.
Ответственность за организацию ипроведение дезинфекционных
(дезинфекция, дезинсекция,
дератизация) и стерилизационных
(предстерилизационная очистка,
стерилизация) мероприятий, за
обучение персонала по данным
вопросам несет руководитель ООМД,
который руководствуется
настоящими санитарными правилами
и другими действующими
нормативно-правовыми документами
29.
Дезинфекция — умерщвление на объектах илиудаление с объектов патогенных или условно
патогенных микроорганизмов и их переносчиков
Предстерилизационная очистка — удаление
загрязнений с изделий медицинского назначения,
подлежащих стерилизации
Стерилизация — процесс
умерщвления на (в)изделиях
микроорганизмов всех видов,
находящихся на всех стадиях
развития
30.
Дезинсекция — комплекс мероприятийнаправленный на уничтожение насекомых
(тараканы, мошки, комары, блохи, клещи,
домашние муравьи, клопы, мухи)
Дератизация — комплекс мероприятий,
направленный на уничтожение грызунов
(крысы, мыши), вредных для человека
в эпидемическом и экономическом отношении
31. Дезинфекция
На эффективность проводимой дезинфекции влияют
различные физические и химические факторы: температура,
концентрация дезраствора, свойства и качество воды,
конфигурация обрабатываемых изделий, массивность
микробного загрязнения и продолжительность обработки
Эффективность проводимой дезинфекции зависит также от
непосредственного контакта раствора с обрабатываемым
материалом, поэтому, перед обработкой необходимо
разобрать инструменты, имеющие узкие щели, каналы,
соединения, чтобы обеспечить доступ дезинфицирующих
агентов ко всем поверхностям изделий
В практических условиях нельзя допускать высыхания на
инструментах остатков органических загрязнений. Высохшие
загрязнения намного труднее поддаются обеззараживанию
и удалению с поверхности инструментов
32. Организация работы персонала ЦСО
Все изделия медицинского назначения ,поступающие на стерилизацию в ЦСО, проходят
несколько этапов технологической цепочки:
приём и разборка
предстерилизационная обработка на различных
типах оборудования
контроль качества обработки
комплектование и упаковка изделий
непосредственно стерилизация
выдача/доставка ИМН в клинические отделения
33. Дезинфекция
Дезинфекции ,ПСО проводимой в ЦСО,
подвергаются все медицинские изделия,
использованные во время операций,
проведении лечебных процедур,
обследовании пациентов
Дезинфекция имеет целью уничтожение
патогенных микроорганизмов
34. Цель ПСО
Предстерилизационная очисткаявляется важным этапом в
подготовке изделий к стерилизации
Предстерилизационная очистка
проводится с целью удаления с
поверхности изделий белковых,
жировых, лекарственных и других
загрязнений
35.
ПРЕДСТЕРИЛИЗАЦИОННАЯ ОЧИСТКАПредстерилизационную
обработку
осуществляют
ручным способом или механизированным с
помощью специального оборудования с применением
моющих растворов.
Механизированная
предстерилизационная
очистка
должна производиться с помощью аппаратов и
оборудования струйным методом, ультразвуком или с
применением моющих средств.
Этапы предстерилизационной очистки ИМН:
-погружение в моющий раствор
-мойка в том же растворе
-ополаскивание проточной водопроводной водой
-высушивание сухим горячим воздухом при t- 85 гр.
36. Способы очистки
Предстерилизационную очисткупроводят ручным или механизированным
(с помощью специального оборудования)
способом
37. Ручной способ
1 этап – погружение в раствор с заполнениемвнутренних каналов и полостей
2 этап – мойка в растворе с помощью щеток,
ершей промывание внутренних каналов и
полостей, обращая внимание на замковые
части и конфигурацию инструмента
3 этап – промывание под проточной водой
4 этап – погружение в дистиллированную
воду с заполнением каналов, полостей
5 этап – высушивание горячим воздухом при
t+85ºС
38. Механизированный способ
Цикл обработки изделий должен включатьтакие этапы, как погружение в раствор
изделий, мойку, ополаскивание водопроводной
водой, ополаскивание деминерализованной
водой и высушивание
Все эти этапы совмещены в современном
моечно – дезинфекционном оборудовании, что
позволяет исключить этап дезинфекции
медицинских изделий на местах, в
подразделениях центра
39. Оборудование используемое для проведения ПСО
Моечнодезинфекционныемашины GETTENG
Ультразвуковая мойка
40. Моечные машины
При использовании моечных машин необходимоопределить их пригодность для очистки каждого
вида инструментов, изучить оптимальные
условия эксплуатации, так как на качество
очистки оказывают влияние конструкция машин,
конфигурация инструмента, применяемые
детергенты и их дозировка, программа цикла
мойки и пр. Результаты этой работы служат
основой для составления регламента по
предстерилизационной очистке - документа,
обязательного для выполнения персоналом ЦСО
41. Ультрозвуковая мойка
Данное оборудование позволяетэффективно очищать инструмент перед
его дальнейшей стерилизацией
Ультрозвуковая обработка
предназначена для мойки мелких
инструментов сложной конфигурации
из нержавеющей стали и жестких
пластмасс
42.
Контроль качества дезинфекции• Химический метод – исследование
рабочих растворов, концентратов на
процентное содержание действующего
вещества (“Дезиконт”)
• Бактериологический метод –
исследование микробной обсемененности
объектов внешней среды на золотистый
стафилококк, синегнойную палочку,
бактерии группы кишечной палочки
43. Контроль качества очистки ИМН проводят путем постановки
Азопирамовой или амидопириновой пробы – на наличиеостаточных компонентов крови
Фенолфталеиновой пробы – на наличие остаточных
количеств щелочных компонентов моющих веществ
(проводится, если pH дезсредства больше, чем 8,0 - 8,5)
Контроль качества предстерилизационной очистки (ПСО)
проводят ежедневно. Контролю подлежат:
в стерилизационной 1% от каждого наименования
изделий, обработанных за смену;
при децентрализованной обработке 1% одновременно
обработанных изделий каждого наименования, но не
менее трех единиц.
Результаты отражают в журнале по форме N 257/у
44.
изделия, давшие положительную пробу накровь или моющее средство,
обрабатываются повторно до получения
отрицательного результата
при повторяющейся положительной пробе
необходимо проверить работу моечно –
дезинфекционного оборудования
45. Стерилизация
Стерилизация (лат. sterilis бесплодный) - полное уничтожениевсех видов микроорганизмов и их спор на поверхности и внутри
различных предметов, а так же в жидкостях и воздухе
Физический метод стерилизации:
Паровой
Воздушный
Радиационный
Химический метод стерилизации:
Газовый
Растворами химических препаратов
Выбор того или иного метода стерилизации зависит от
особенностей стерилизуемого объекта и самого метода, выбранные
методы средства и режимы стерилизации не должны вызывать
изменений внешнего вида, прочности, эксплуатационных качеств и
других свойств стерилизуемых изделий
46. Паровой метод стерилизации
Стерилизация паровым методомпроводится в паровых
стерилизаторах (автоклавах),
которые работают под избыточным
давлением
Во время стерилизации пар не
вступает в реакцию со
стерилизуемым материалом,
не оставляет осадка на изделиях
Метод является достаточно
экономичным и с точки зрения
экологии –наименее вредным
Недостаток- вызывает коррозию,
увлажняет материалы, увеличивает
опасность реинфицирования
простерилизованных изделий
47. Воздушный метод стерилизации
Стерилизация сухим горячим воздухом рекомендуется вслучаях, когда отсутствует паровая стерилизация, или
когда необходимо стерилизовать изделия (материалы),
которые не могут стерилизоваться паром под давлением
При воздействии сухого горячего воздуха не
происходит увлажнения упаковок и изделий, не
наблюдается коррозии инструментов
Простота использования, доступность, экономичность
позволяет применять в любой МО
Гибель микроорганизмов под действием сухого жара
наступает гораздо медленнее, чем под влиянием пара
при тех же температурах
48. Воздушный стерилизатор ГП -80
49.
1. Газовая стерилизация при помощи формальдегидаНизкая проникающая способность формальдегида приводит к тому ,что
данный метод требует применения рабочей температуры в пределах 65-80С,
в связи с чем, этот метод нельзя считать низкотемпературным
Имеются ограничения в отношении стерилизации полых изделий, изделий с
отверстиями и каналами. Не разработано нейтрализаторов и полного
мониторинга процесса стерилизации
2. Газовая стерилизация с помощью этиленоксида
Обеспечивает самый щадящий температурный режим стерилизации,
обладает высокой проницаемостью, не вступает в реакцию с большинством
материалов используемых в медицине, что позволяет стерилизовать
практически все мед.приборы и расходные материалы в любой упаковке, не
разрушая их структуру
Требуется время для аэрации. Окись этилена токсична, является
канцерогеном, легко воспламеняется, взрывоопасна
50. Плазменная стерилизация
Принцип данной технологии заключается ввоздействии стерилизующего агента на основе
пероксида водорода на стерилизуемые
изделия, что приводит к нарушению процессов
жизнедеятельности
При этом уничтожаются все формы
микроорганизмов, включая их условнопатогенные виды, которые активно проявляют
себя в госпитальной инфекции
51. Плазменная стерилизация
Безопасность для больных иперсонала
Короткий цикл и отсутствие
аэрации – быстрый оборот
инструментов, больше операций
Полностью автоматизированный
процесс – прост в использовании,
отсутствие человеческого фактора
Надёжность и безопасность
процесса – цикл проходит при
пониженном давлении
Щадящее воздействие на
инструменты
Широкий спектр совместимости
Снижение риска госпитальных
инфекций
52. Радиационная стерилизация
Стерилизующим агентом при использовании этогометода является гамма- и бета-излучения
Эффективность радиационной стерилизации зависит от
общей дозы излучения и не зависит от времени
Основными достоинствами являются: высокая степень
инактивации микроорганизмов, возможность
стерилизации больших партий материалов,
автоматизация процесса, стерилизация изделий в любой
герметичной упаковке и товарной таре
Используется для промышленной стерилизации
одноразовых изделий
В МО не применяется в связи с большой дороговизной и
по соображениям техники безопасности
53. Контроль эффективности стерилизации
Контроль эффективности работыстерилизационного оборудования
осуществляется следующими методами:
Физическим
Химическим
Бактериологическим
54. Физический метод:
Осуществляется с помощью средствизмерения
Температуры – термометры
Давления – манометры
Времени – таймеры
Современные конструкции стерилизаторов оснащены
также записывающими устройствами, фиксирующими на
диаграмме температуру и давление каждого цикла
стерилизации
55. Химический метод – проводится с помощью химических индикаторов
Индикаторы 1 класса – индикаторы внешнего ивнутреннего процесса(термоиндикаторная лента),
изменение цвета указывает, что упаковка подверглась
воздействию процесса стерилизации
Индикаторы 2 класса – используется в специальных
тестовых процедурах (Бови-Дик, тест-трубчатой
загрузки) оценивает эффективность работы
вакуумного насоса, и устанавливает наличие воздуха в
камере парового стерилизатора
Индикаторы 3 класса – индикаторы одного параметра.
Они оценивают минимальную температуру, но не дают
представления о времени воздействия температуры
(бензойная к-та и др.)
56.
Индикаторы 4 класса – это многопараметровыеиндикаторы. Они одержат красители, изменяющие
цвет при сочетанном воздействии нескольких
параметров стерилизации
Индикаторы 5 класса – интегрирующие индикаторы.
Эти индикаторы реагируют на все основные
параметры стерилизации. По определению ISO
характеристика этого класса индикаторов
сравнивается с инактивацией высокорезистентных
микроорганизмов (можно использовать также, как
биотесты)
Индикаторы 6 класс – интегратор-эмулятор
реагирует только тогда, когда пройдёт не менее
95% цикла стерилизации
57. Бактериологический метод
Является более надёжным, предназначен дляконтроля эффективности стерилизационного
оборудования
Для проведения бактериологического
контроля используются биотесты, имеющие
дозированное количество спор тест-культуры
Данный метод проводится 1 раз в полгода, а
также после ТО и ремонта оборудования
58.
Инфекционный процесс– взаимодействие макро- и
микроорганизмов, способствующее
возникновению инфекционной болезни
Цепочка ИП:
возбудитель +
факторы и пути передачи +
восприимчивый организм
59.
Инфекционная безопасность- это комплексное понятие, определяющее
организацию медицинской помощи населению в
плане профилактики инфекционных
заболеваний, создание комфортных и
безопасных условий пребывания и лечения
пациентов в ООМД, а также профессиональной
деятельности медицинского персонала
60.
Инфекционная безопасность включает:– ИБ медработников (средства защиты, стандарты,
прививки, медосмотры)
– ИБ пациентов (нормативно-правовые документы,
направленные на профилактику ВБИ)
– ИБ окружающей среды (утилизация отходов)
61.
Технологии инфекционной безопасности:• противоэпидемические
• санитарно-гигиенические
• лечебно-профилактические
• дезинфекционные, дератизационные и
дезинсекционные
62.
Инфекционный контроль- это система организационных,
профилактических и
противоэпидемических мероприятий,
направленных на предупреждение
возникновения и распространения
инфекционных заболеваний в стационаре,
которая базируется на результатах
эпидемиологической диагностики
63.
Внутрибольничная инфекция (ВБИ) –«госпитальная, больничная,
нозокомиальная» - любое клинически
выраженное заболевание микробного
происхождения, которое поражает больного
в результате его поступления в больницу
или обращения за медицинской помощью, а
также заболевание сотрудника больницы
вследствие его работы в данном
учреждении, вне зависимости от появления
симптомов заболевания во время
пребывания или после выписки из больницы
(Европейское региональное бюро ВОЗ, 1979 г)
64.
Инфекция, связанная с оказаниеммедицинской помощи (ИСМП)
– случаи инфекции связанные с оказанием
любых видов медицинской помощи, а
также случаи инфицирования
медицинских работников в результате их
профессиональной деятельности
(ФЗ «Основы охраны здоровья граждан»)
65.
СанПиН 3.3686-21 раздел XXXII п. 3394К инфекциям, связанным с оказанием медицинской
помощи (ИСМП), относят любое инфекционное
заболевание, развившееся у пациента в связи с
оказанием ему любых видов медицинской помощи (в
медицинских организациях, осуществляющих оказание
медицинской помощи в стационарных условиях,
амбулаторно, в том числе на дому, в условиях
дневного стационара и вне медицинской организации,
в организациях социального обслуживания, в
организациях,
осуществляющих
образовательную
деятельность,
санаторно-оздоровительных
организациях и других), а также случаи заражения
инфекционными болезнями медицинских работников в
результате их профессиональной деятельности
66. Внутрибольничные инфекции (ВБИ)
представляютсобой
любые
инфекционные
заболевания (состояния), возникшие в МО (и не
имевшиеся до обращения за медицинской помощью,
в том числе в инкубационном периоде) и
проявившиеся в условиях МО или вне МО в течение
периода
инкубации,
а
также
инфекционное
заболевание (состояние) сотрудника МО вследствие
его инфицирования при выполнении трудовых
обязанностей
являются частью ИСМП
диагноз устанавливается на основании
эпидемиологических, клинических и лабораторных
данных
67. Среди возбудителей ИСМП идентифицируют:
бактерии: Staphylococcus spp., Streptococcus spp., Enterococcusspp., Pseudomonas spp., Escherichia spp., Klebsiella spp.,
Enterobacter spp., Acinetobacter spp., Serratia spp., Proteus spp.,
Citrobacter spp., Clostridium spp., Mycobacterium spp., Salmonella
spp., Shigella spp., Yersinia spp., Legionella spp. и другие;
вирусы: ВИЧ, вирусы гепатитов B, C, D, A, ротавирусы,
норовирусы, энтеровирусы, вирусы гриппа и других ОРВИ, кори,
краснухи, эпидемического паротита, герпеса,
цитомегаловирусы, коронавирусы (SARS-CoV, MERS-CoV) и
другие;
грибы: Candida spp., Aspergillus spp. и другие;
простейшие: Cryptosporidium spp., Pneumocystis carinii и другие
эктопаразиты: Pediculus spp.; Sarcoptes scabiei и другие
68.
Пути передачи инфекцииЭндогенный – собственная микрофлора пациента
(возникает, развивается в организме в следствие внутренних
причин, внутренних факторов)
Экзогенный – возникающий в результате
воздействия внешних факторов
-
-
- пищевой
- водный
- контактно-бытовой
- воздушно-капельный
- воздушно-пылевой
69.
При возникновении ИСМП,обусловленных патогенными
микроорганизмами, требуется
проведение противоэпидемических
мероприятий согласно требованиям
Санитарных правил к профилактике
отдельных инфекционных болезней
СанПиН 3.3686-21
70. Основными формами ИСМП являются:
Гнойно-септические инфекции новорожденных (ГСИноворожденных): бактериальный менингит, сепсис,
остеомиелит, омфалит, инфекции кровотока, пиодермия,
импетиго, панариций, паронихий, мастит, неонатальная
инфекция мочевых путей, конъюнктивит и дакриоцистит,
пневмонии
Гнойно-септические инфекции родильниц (ГСИ родильниц):
сепсис, инфекции соска и молочной железы, связанные с
деторождением, острый перитонит, инфекция
хирургической акушерской раны, расхождение швов после
кесарева сечения, расхождение швов промежности,
инфекции мочевых путей после родов, инфекции органов
дыхания, осложняющие роды и послеродовой период
71. Основными формами ИСМП являются:
Инфекции в области хирургического вмешательства(ИОХВ)
Инфекции кровотока (ИК): инфекции, связанные с
инфузией, трансфузией и лечебной инъекцией,
иммунизацией. Среди инфекций кровотока выделяют
катетер-ассоциированные инфекции кровотока (КАИК)
Инфекции мочевыводящих путей (ИМВП). Среди них
выделяют катетер-ассоциированные инфекции
мочевыводящих путей
Инфеции нижних дыхательных путей (ИНДП). Среди
них выделяют ИВЛ-ассоциированные ИНДП
72. Основными формами ИСМП являются:
Острые кишечные инфекции (ОКИ), в том числе острыегепатиты A и E
Другие сальмонеллезные инфекции
Воздушно-капельные инфекции (ВКИ)
Туберкулез впервые выявленный, активные формы
Парентеральные инфекции: ВИЧ, гепатиты B и C
73.
Случаиинфекционных
заболеваний,
возникшие до поступления в МО,
проявившиеся или выявленные при
поступлении
(после
поступления
в
пределах инкубационного периода данной
нозологической
формы),
называются
заносами инфекции и не относятся к
ИСМП.
При
заносе
инфекционных
заболеваний
необходимо
проводить
комплекс
противоэпидемических
мероприятий
согласно
требованиям
Санитарных правил к профилактике
отдельных инфекционных болезней
74. Источники ИСМП
пациентымедицинские работники
лица, ухаживающие за больными, и
посетители
Наиболее значимыми источниками инфекции являются больные
манифестными формами, в том числе внутриутробного
характера заражения (ВУИ), носители антибиотикорезистентных
штаммов микроорганизмов, а также медицинский персонал с
патологией
верхних
и
нижних
дыхательных
путей,
мочевыводящего и желудочно-кишечного трактов, кожи и
подкожной клетчатки
75. Механизмы передачи ИСМП:
естественный (фекально-оральный,аспирационный, контактный,
транслокация)
искусственный (артифициальный:
ассоциированный с инвазивными и
неинвазивными лечебнодиагностическими процедурами и
манипуляциями, в том числе
трансплантация органов, тканей)
76. Факторы передачи
рукимедперсонала, белье, медицинское
оборудование (аппараты ИВЛ, гемодиализа,
эндоскопы и другие), инструменты, средства
ухода за больными, инъекционные растворы
(в первую очередь в многодозовых флаконах),
повторно
используемые
одноразовые
медицинские изделия, воздух и другие
Руки
персонала
играют
наибольшее
эпидемиологическое значение в передаче
инфекции (более 50%)
77. Причины, способствующим росту заболеваемости ИСМП
нарушения в организации работы МО (превышение нормкоечной емкости палат; отсутствие разделения по
нозологическим формам; совместное размещение детей и
взрослых пациентов);
санитарно-техническом состоянии (аварийные ситуации на
водопроводной и канализационной системах, перебои и
отсутствие в подаче горячей и холодной воды, нарушения в
тепло- и энергоснабжении);
материальном обеспечении (недостаток медицинских
изделий, в том числе одноразовых катетеры, санационные
системы, дыхательные трубки и другие; нехватка
оборудования, перевязочного материала, лекарств; перебои
в поставке белья, моющих и дезинфицирующих средств)
78. Причины, способствующим росту заболеваемости ИСМП
не соблюдение противоэпидемического режима(несоблюдение цикличности заполнения палат;
несвоевременный перевод новорожденных и родильниц в
соответствующие стационары; повторное использование
одноразовых медицинских изделий, неиндивидуальное
использование средств ухода за больными, емкостей для
питья, кормления, обработки кожных покровов и глаз;
нарушение правил текущей и заключительной дезинфекции,
стерилизации и другие)
неудовлетворительные архитектурно-планировочные
решения: несоответствие состава и площади помещений;
перекрест технологических потоков; отсутствие
механической приточно-вытяжной вентиляции
79. Распространенность и смертность, связанная с ИСМП
Согласно позиции ВОЗ ни один тип учреждения здравоохраненияни в одной стране не может претендовать на то, чтобы быть
свободным от риска возникновения инфекций, связанных с
оказанием медицинской помощи
В то же время заболеваемость может быть минимизирована путем
управления рисками их возникновения и распространения
По данным Европейского Центра по контролю и профилактике
заболеваний 4 131 000 пациентов поражаются ежегодно ИСМП в
Европе, что соответствует распространённости ИСМП в 7,1% (515%). Экономический ущерб в странах Европы - 13–24 миллиарда
евро; в Великобритании - около 10 млрд. фунтов стерлингов.
ИСМП занимают 10-е место среди ведущих причин смерти в США.
По данным Центров по контролю за болезнями (CDC), число
случаев ИСМП ежегодно составляет 1,7 миллионов случаев, из
которых 99 тыс. со смертельным исходом, и экономический ущерб
составляет около 30 млрд. долларов;
80. Выявление, учет и регистрация случаев ИСМП
Случаи ИСМП подлежат регистрации, учету и статистическомунаблюдению
Руководители медицинских организаций, выявивших больного,
должны обеспечить полноту, достоверность и своевременность
учета случая ИСМП, а также оперативное сообщение о них в
территориальный орган, уполномоченный осуществлять
федеральный государственный санитарно-эпидемиологический
надзор
Каждый случай ИСМП подлежит регистрации в журнале учета
инфекционных заболеваний (форма 060/у) по месту их выявления и
месту инфицирования пациента в медицинских организациях, а
также в территориальных органах, уполномоченных осуществлять
федеральный государственный санитарно-эпидемиологический
надзор. Учет всех случаев ИСМП ведется по месту инфицирования
пациента
81. Выявление, учет и регистрация случаев ИСМП
В случае выявления ИСМП после выписки или перевода пациента вдругой стационар, МО, выявившая ИСМП, должна передавать
информацию в территориальные органы, уполномоченные
осуществлять федеральный государственный санитарноэпидемиологический надзор, которые в течение 12 часов передают
информацию о зарегистрированных ИСМП в МО по месту
предполагаемого инфицирования
Групповыми заболеваниями следует считать 5 и более случаев
ИСМП, связанных одним источником инфекции и (или) общими
факторами передачи, в том числе заражение среди пациентов и
персонала (суммарно)
О возникновении групповых заболеваний ИСМП любой этиологии
МО сообщает в органы, уполномоченные осуществлять
федеральный государственный санитарно-эпидемиологический
надзор в соответствии с установленным порядком представления
внеочередных донесений о чрезвычайных ситуациях санитарноэпидемиологического характера
82. Выявление, учет и регистрация случаев ИСМП
Заболевания новорожденных инфекциями, вызванные условнопатогенной флорой и выявленные в период пребывания в
акушерском стационаре и (или) в течение 7 дней после выписки,
подлежат учету в данном стационаре. Генерализованные формы
(сепсис, гематогенный остеомиелит, менингит) учитываются в
течение месяца после рождения ребенка
Заболевания родильниц инфекциями, вызванные условно
патогенными микроорганизмами и связанные с родами (эндометрит,
пиелонефрит, гнойный мастит, сепсис, перитонит и другие),
выявленные в период пребывания в акушерском стационаре и (или)
в течение 30 дней после родов, подлежат учету акушерским
стационаром
Гнойно-воспалительные заболевания, связанные с оказанием
хирургической медицинской помощи (ИОХВ), имеют максимальный
инкубационный период 30 календарных дней после оперативного
вмешательства, а при наличии имплантата в месте операции - год и
более
83. в Российской Федерации
ежегоднорегистрируется 26-30 тыс. случаев
(5-15%)
Согласно данным выборочных исследований,
проведенных на базе 58 МО в восьми регионах
6,7% пациентов имели ИСМП
Предполагаемая
ежегодная заболеваемость
пациентов в стационарах составляет 2-2,5 млн.
человек
Экономический ущерб – 10-15 млрд. руб.
84.
Асептика – комплекс мероприятий, направленныхна предупреждение попадания микроорганизмов
в рану
Антисептика (лат. anti — против, septicusгниение)– система мероприятий, направленных
на уничтожение микроорганизмов в ране,
патологическом очаге, органах и тканях,
а также в организме больного в целом,
использующая механические
и физические методы воздействия,
активные химические вещества
и биологические факторы
85.
Контаминация –(лат. contaminatio - смешение, вплетение)
- попадание в определённую среду
примеси (например, токсичного вещества
или другого штамма микроорганизмов),
изменяющей свойства данной среды, а
также загрязнение кожи и слизистых
оболочек организма
86.
Деконтаминация –общий
термин,
под
которым
понимается процесс обработки, при
котором
происходит
удаление
возбудителей
инфекционных
заболеваний, в результате чего
использование
обработанного
предмета становится безопасным
87.
Состав аптечки «Анти-ВИЧ»Приказ Министерства здравоохранения Российской
Федерации от 09.01.2018 № 1н "Об утверждении
требований к комплектации лекарственными
препаратами и медицинскими изделиями укладки
экстренной профилактики парентеральных
инфекций для оказания первичной медикосанитарной помощи, скорой медицинской помощи,
специализированной медицинской помощи и
паллиативной медицинской помощи"
Вступил в силу 23 марта 2018 г.
* Этанол – 70% - 100,0
* Йод – 5%
*Лейкопластырь бактерицидный (не менее 1,9х7,2 см) – 3 шт.
*Бинт марлевый медицинский стерильный (5м х 10 м) – 2 шт.
*Салфетка марлевая мед.стер (не менее 16х14 см № 10) – 1 уп.
88.
Требованияк комплектации укладки экстренной
профилактики парентеральных инфекций
1 Лекарственные препараты
N
Код АТХ
Анатомо-терапевтическохимическая классификация
(АТХ)
1.1
Лекарственный препарат
Лекарственная форма
Антисептики и дезинфицирующие средства
1.1.1
D08AG03
Йод
йод [калия йодид + этанол] раствор для наружного
применения 5 %
1.1.2
D08AX08
Этанол
Этанол
раствор для наружного
применения 70 %
Медицинские изделия
N
Наименование медицинского изделия
Кол-во, не менее
2.1
Бинт марлевый медицинский стерильный (5 м х 10 см)
2 шт.
2.2
Лейкопластырь бактерицидный (не менее 1,9 см х 7,2 см)
3 шт.
2.3
Салфетка марлевая медицинская стерильная (не менее 16
см х 14 см, N 10)
1 уп.
89.
При аварийной ситуации медицинскому работникунеобходимо осуществлять следующие
мероприятия:
СанПиН 3.3686-21 Профилактика ВИЧ-инфекции п.675
в случае порезов и уколов
- немедленно снять перчатки
- вымыть руки с мылом под проточной
водой
- обработать руки 70%-м спиртом
- смазать ранку 5%-м спиртовым
раствором йода
90. При аварийной ситуации медицинскому работнику необходимо осуществлять следующие мероприятия: СанПиН 3.3686-21 Профилактика
ВИЧ-инфекции п.675при попадании крови или других
биологических жидкостей на кожные
покровы
- это место обрабатывают 70%-м спиртом
- обмывают водой с мылом
- и повторно обрабатывают 70%-м
спиртом
91. При аварийной ситуации медицинскому работнику необходимо осуществлять следующие мероприятия: СанПиН 3.3686-21 Профилактика
При аварийной ситуации медицинскому работникунеобходимо осуществлять следующие
мероприятия:
при попадании крови и других
биологических жидкостей пациента
на слизистую глаз, носа и рта:
- ротовую полость, слизистую
оболочку носа и глаз обильно
промывают водой (не тереть)
92. При аварийной ситуации медицинскому работнику необходимо осуществлять следующие мероприятия:
при попадании крови и другихбиологических жидкостей пациента
на халат, одежду:
- снять рабочую одежду и погрузить в
дезинфицирующий раствор или в
бикс (бак) для автоклавирования;
93. При аварийной ситуации медицинскому работнику необходимо осуществлять следующие мероприятия:
при наличии риска заражения ВИЧ-инфекцией незамедлительно начать
прием антиретровирусных препаратов
в целях постконтактной профилактики
заражения ВИЧ
94. При аварийной ситуации медицинскому работнику необходимо осуществлять следующие мероприятия:
Согласно п. 676- 685. Необходимонезамедлительно после контакта
обследовать на ВИЧ и вирусные гепатиты
B и C лицо, которое может являться
потенциальным источником заражения и
контактировавшее с ним лицо.
95.
Обследование на ВИЧ потенциального источникаВИЧ-инфекции и контактировавшего лица
проводят методом экспресс-тестирования на
антитела к ВИЧ (в лаборатории МО) после
аварийной ситуации с обязательным
направлением образца крови для стандартного
тестирования на ВИЧ в диагностических тестах,
одновременно выявляющих антитела к ВИЧ 1,2 и
антиген p24.
Образцы плазмы (или сыворотки) крови человека,
являющегося потенциальным источником
заражения, и контактного лица, передают для
хранения в течение 12 месяцев
в КГБУЗ «ЦПБСИЗ» ул. Пилотов, 2.
96.
Пострадавшего и лицо, которое может являться потенциальнымисточником заражения, необходимо опросить о
-носительстве вирусных гепатитов
-ИППП
- воспалительных заболеваний мочеполовой сферы, других
заболеваний
-провести консультирование относительно менее
рискованного поведения.
Если источник инфицирован ВИЧ, выясняют, получал ли он
антиретровирусную терапию.
Если пострадавшая - женщина, необходимо провести
тест на беременность (в лаборатории МО) и выяснить, не
кормит ли она грудью ребенка.
При отсутствии уточняющих данных постконтактную
профилактику начинают незамедлительно, при появлении
дополнительной информации схема корректируется.
97.
Проведение постконтактной профилактикизаражения ВИЧ антиретровирусными
препаратами:
прием антиретровирусных препаратов,
который должен быть начат в течение первых
двух часов после аварии, но не позднее 72 часов
согласно схемам профилактики
(3-мя и более антиретровирусными препаратами в
течение 4 недель).
Для организации диспансерного наблюдения
и корректирования схем химиопрофилактики ВИЧинфекции пострадавший в день обращения
должен быть направлен в
КГБУЗ «ЦПБСИЗ» ул. Пилотов, 2.
98.
Срок диспансерного наблюдения пациентов,пострадавших в аварийных ситуациях, связанных с
риском инфицирования ВИЧ, составляет 1 год
Периодичность обследования на антитела к ВИЧ
(метод иммуноферментного анализа):
-в день (ближайшие дни после) аварийной ситуации
- в дальнейшем через 3, 6, 12 месяцев после
аварии
Пострадавший должен быть предупрежден о том,
что он может быть источником инфекции в
течение всего периода наблюдения (максимально
возможного инкубационного периода) и поэтому
ему надлежит соблюдать меры предосторожности,
чтобы избежать возможной передачи ВИЧинфекции.
99.
По истечении года при отрицательныхрезультатах лабораторных исследований
пострадавший снимается с диспансерного
наблюдения.
В случае получения положительного результата
проводится расследование причин
возникновения
у работника
профессионального
заболевания.
100.
При наступлении аварийной ситуации, повлекшейза собой риск заражения ВИЧ-инфекцией,
сотрудники медицинских организаций должны
незамедлительно сообщать о каждом аварийном
случае руководителю отделения
(подразделения), его заместителю,
вышестоящему руководителю.
Аварийные ситуации учитываются в каждом
отделении (подразделении) в
журнале учета аварийных
ситуаций при проведении
медицинских манипуляций
101.
Обеззараживаниемедицинских
отходов
Медицинские отходы в зависимости от степени их
эпидемиологической, токсикологической и радиационной
опасности, а также негативного воздействия на среду
обитания подразделяются на пять классов опасности:
Класс А – эпидемиологически безопасные отходы,
приближенные по составу к твердым бытовым
отходам
Класс Б – эпидемиологически опасные отходы
Класс В – чрезвычайно эпидемиологически
опасные отходы
Класс Г – токсикологически опасные отходы 1-4
классов опасности
Класс Д – радиоактивные отходы
102.
103.
104.
105.
106.
107.
Обеззараживание рукмедицинских
работников и кожных
покровов пациентов при
оказании медицинской
помощи
МУ 3.5.1. 3674-20
В целях
профилактик
и ИСМП
обеззаражив
анию
подлежат
руки
медицинских
работников
108. Обеззараживание рук медицинских работников и кожных покровов пациентов при оказании медицинской помощи МУ 3.5.1. 3674-20
Для достиженияэффективного мытья и
обеззараживания рук
необходимость соблюдения условий:
коротко подстриженные ногти
отсутствие лака на ногтях
отсутствие искусственных ногтей
отсутствие на руках колец, перстней и
других ювелирных украшений
109. Для достижения эффективного мытья и обеззараживания рук
Для высушиваниярук применяют
чистые тканевые
полотенца или
бумажные
салфетки
однократного
использования
110.
Гигиеническуюобработку рук следует
проводить в следующих
случаях:
- перед
непосредственным
контактом с
пациентом;
- после контакта с
неповрежденной
кожей пациента
(например, при
измерении пульса или
артериального
давления);
111. Гигиеническую обработку рук следует проводить в следующих случаях:
- после контакта смедицинским
оборудованием и
другими объектами,
находящимися в
непосредственной
близости от пациента;
- после лечения
пациентов с гнойными
воспалительными
процессами, после
112. Гигиеническую обработку рук следует проводить в следующих случаях:
Гигиеническаяобработка рук
проводится двумя
способами:
1. гигиеническое мытье
рук мылом и водой для
удаления
загрязнений и
снижения количества
микроорганизмов
2. обработка рук кожным
антисептиком для
113. Гигиеническая обработка рук проводится двумя способами:
гигиеническое мытье рукмылом и водой
1. Подготовка к процедуре:
- Проверить целостность кожи
- Снять с рук все украшения, часы
- Открыть кран, отрегулировать напор и
температуру воды (+37ºС)
- Нанести на влажные руки 3-5 мл жидкого
мыла (см. инструкцию), вспенить
114. гигиеническое мытье рук мылом и водой
2.используя
следующую
технику
Выполнени
е
процедуры
(каждое
движение
повторяет
ся не менее
5 раз,
обработка
115. Вымыть руки, используя следующую технику
Вымыть руки, используяследующую технику:
2.1. Тереть
одну
ладонь о
другую
ладонь
возврат
нопоступа
тельным
и
116. Вымыть руки, используя следующую технику:
2.2. Вращательнымидвижениями
правой руки тереть
левое запястье,
поменять руки
117. Вымыть руки, используя следующую технику:
2.3. Правой ладоньюрастирать тыльную
поверхность левой
кисти, поменять
руки
118. Вымыть руки, используя следующую технику:
2.4.ладонь
к
ладони
со
скреще
нными
пальца
ми
119. Вымыть руки, используя следующую технику:
120.
Вымыть руки, используяследующую технику:
2.5.
Соединить
пальцы в
«замок»,
тыльной
стороной
согнутых
пальцев
растирать
121. Вымыть руки, используя следующую технику:
2.5. Охватитьоснование
большого
пальца
левой
кисти
между
большим и
указательн
ым
пальцами
правой
122. Вымыть руки, используя следующую технику:
2.6.Круговы
м
движени
ем
тереть
ладонь
левой
кисти
кончика
123. Вымыть руки, используя следующую технику:
3. Окончание процедуры3.1. промыть руки под проточной водой,
держа их так, чтобы запястья и кисти были
ниже уровня локтей, выполняя те же
движения, что и в основной части
3.2. осушить руки чистыми тканевыми
полотенцами или бумажными салфетками
однократного использования
(при необходимости использовать несколько штук)
3.3. закрыть кран
124. 3. Окончание процедуры
125.
Гигиеническаяобработка рук
антисептиком
Антисептический препарат наливают в
углубление ладони и в течение 30 секунд
энергично втирают в кожу рук, включая
запястья, до полного высыхания
При необходимости повторить втирание
новой порции антисептика
На протяжении всего времени втирания руки
должны оставаться влажными от препарата
126. Гигиеническая обработка рук антисептиком
127.
Этот способ обработки рук можноприменять и без предварительного
мытья рук, в случае, если нет
видимого загрязнения кожных
покровов
128.
Кожные антисептики дляобработки рук должны
быть легко доступны на
всех этапах
диагностического
процесса. В
подразделениях с
высокой
интенсивностью ухода
за пациентами и с
высокой нагрузкой на
129.
Кожные антисептики для обработки рукдолжны быть легко доступны на всех этапах
лечебно-диагностического процесса. В
подразделениях с высокой интенсивностью
ухода за пациентами и нагрузкой на персонал
(отделения реанимации и интенсивной
терапии и т. п.) дозаторы с кожными
антисептиками для обработки рук должны
размещаться в удобных для применения
персоналом местах (у входа в палату, у
постели больного и др.). Следует также
предусматривать возможность обеспечения
медицинских работников индивидуальными
емкостями (флаконами) небольших объемов
(100—200 мл) с кожным антисептиком
130.
Обработкапроводится в два
этапа
I этап – мытье
рук мылом и
водой в течение
двух минут, а
затем
высушивание
стерильным
полотенцем
(салфеткой)
131. Обработка проводится в два этапа
II этап- обработка
антисептиком
кистей рук,
запястий и
предплечий.
Количество
антисептика
определяется
инструкцией по
применению
132. Обработка проводится в два этапа
Стерильныеперчатки
надевают сразу
после полного
высыхания
антисептика на
коже рук
133.
134.
МР 3.5.1.0113-16« Использование перчаток для
профилактики инфекций,
связанных с оказанием
медицинской помощи, в
медицинских организациях»
135.
Правила личной гигиены медперсонала• Ежедневный душ или ванна
• Ношение чистой одежды
• Волосы должны быть чистыми и забранными
• Руки должны быть чистыми, ногти должны быть
подстрижены, лак на ногтях и искусственные ногти не
разрешаются
• Ношение ювелирных изделий должно быть сокращено до
минимума, ювелирные изделия мешают тщательному
мытью рук
• Необходимо прикрывать нос и рот бумажным носовым
платком при чихании или кашле
• Нахождение в медицинской одежде и обуви за пределами
МО не допускается
• Прием пищи персоналом проводится в специально
отведенных помещениях, на рабочем месте принимать
пищу запрещено
136.
Правила личной гигиены медперсоналаСмена одежды в подразделениях хирургического и
акушерского профиля осуществляется ежедневно и по
мере загрязнения
В учреждениях терапевтического профиля — 2 раза в
неделю и по мере загрязнения
• Сменная обувь персонала, работающего в помещениях с
асептическим режимом должна быть из нетканого
материала, доступного для дезинфекции
• Сменная одежда и обувь должна быть предусмотрена
также и для медицинского персонала других
подразделений, а также для инженерно-технических
работников
• В ходе проведения манипуляций пациенту персонал не
должен вести записи, прикасаться к телефонной
трубке
137.
Требования к правилам личной гигиены пациентов• Гигиеническая обработка больных (при отсутствии
медицинских противопоказаний) и осмотр на
педикулез должны осуществляться не реже 1 раза в
7 дней с отметкой в истории болезни
• Гигиенический уход за тяжелобольными (умывание,
протирание кожи лица, частей тела, полоскание
полости рта) проводится утром, а также после
приема пищи и при загрязнении тела
Периодически должны быть организованы стрижка и
бритье больных
• Смена белья пациентам должна проводиться по мере
загрязнения, регулярно, но не реже 1 раза в 7 дней.
Загрязненное белье подлежит незамедлительной
замене
138.
139.
140.
141.
142.
143.
Благодарю за внимание!16 сентября 2022 года
Волочаева М.В.

medicine
medicine








